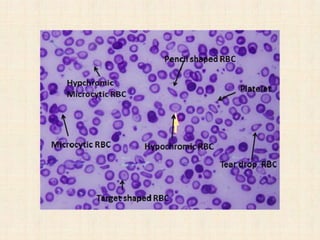

The document provides information on evaluating and managing pallor or paleness in patients. It discusses examining common areas like the palms, conjunctiva, and mucous membranes for pallor. The causes of pallor are categorized as either sudden or long-lasting, and examples are given for each category. Specific conditions that can cause localized or generalized pallor are also outlined. The approach involves taking a thorough history and physical exam and selecting appropriate lab tests to determine the underlying cause of anemia or pallor.